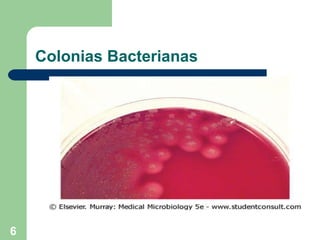
Colonias Bacterianas
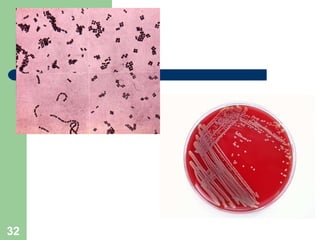

El documento resume las características principales de los estafilococos, incluyendo su morfología, hábitat natural, factores de patogenicidad y los síndromes clínicos que pueden causar. Los estafilococos más importantes médicamente son S. aureus y S. epidermidis. S. aureus es el principal patógeno y causa infecciones que van desde leves hasta sistémicas graves. Produce diversas toxinas que causan síndromes como el impétigo, el shock tóxico y la intoxicación alimentaria.